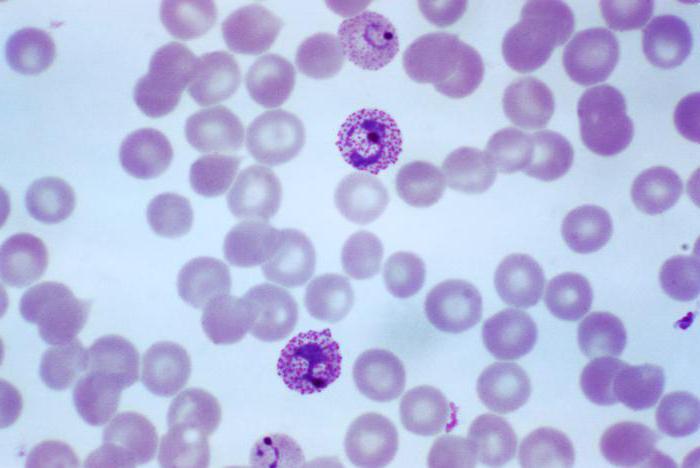

Малярия – это серьезное заболевание, иногда заканчивающееся смертельным исходом. У людей, заразившихся ею, как правило, возникают тяжелые симптомы, среди которых озноб, лихорадка, гриппоподобные состояния. Заболевание малярия имеет большую вероятность летального исхода. Тем не менее, своевременное и правильное лечение может это предотвратить. Возбудителем малярии является плазмодий, живущий в организме определенного вида комара, который питается кровью человека. Ниже этот вопрос будет рассмотрен более подробно. Информацию о лечении и профилактике болезни вы найдете в данной публикации.
История
Пытливые умы человечества всегда искали способы излечения от всевозможных недугов. К каким только методам не прибегали для терапии малярии в древние времена: кровопускание, ампутация укушенной конечности, использование опийных средств. Привлекали даже астрологов, которые связывали периодичность возникновения малярийных лихорадок с астрономическими явлениями и положением звезд на небе. Многие обращались к колдовству. Ученый Альберт Магнус, доминиканец, предлагал лечить малярию путем съедания маленьких булочек, приготовленных из муки и мочи больного человека, а также выпивая напиток, в состав которого входили коньяк, кровь зараженного и перец.
Древнегреческий врач Гален, который работал в Риме, предполагал, что рвота, которая появляется при малярии, является попыткой организма выгнать яды наружу, а кровопускание ускоряет излечение. Эти принципы главенствовали в медицине на протяжении пятнадцати сотен лет. Бесчисленное множество больных малярией было подвергнуто кровопусканию и принудительному очищению желудка и кишечника посредством клизмы и рвоты. Это приводило к катастрофическим результатам: люди умирали от анемии и обезвоживания, а также от разрушительных симптомов малярии в еще более короткие сроки.
В Китае во 2 веке до н.э. в трудах медиков было описано растение артемизия, или сладкая полынь, которое применяли в качестве средства от малярии. Интересно, что в 1971 году китайские ученые выделили из него активный ингредиент — артемизин. Во время войны во Вьетнаме проводились активные работы по изучению противомалярийных свойств сладкой полыни. Экстрактом растения кормили лабораторных мышей и крыс, инфицированных штаммами малярии. Артемизинин оказался достаточно эффективным, так же, как хинин и хлорохин. Производные этого вещества сегодня входят в состав мощных и эффективных противомалярийных препаратов.
Вид плазмодия, вызывающий развитие малярии, впервые был обнаружен французским медиком и ученым Лавераном в конце 19 века. Русские исследователи внесли огромный вклад в изучение болезни и разработку методов ее устранения. Среди этих ученых стоит отметить Е.И. Марциновского, В.А. Данилевского, С.П. Боткина. В периоды Первой и Второй мировых войн были отмечены всплески заболеваемости малярией.
Из двухста существующих видов паразитических простейших рода Плазмодиум малярию вызывают как минимум десять. Среди них P. ovalecurtisi, P. wallikeri, P. vivax, P. malariae, P. knowlesi. Наиболее тяжелую и опасную в плане смертности малярию вызывают микроорганизмы P. knowlesi и P. falciparumand. Инфекция, приводящая к развитию болезни, передается исключительно комарами рода Анофелес. Заражение малярией становится более вероятным во время активных поездок по всему миру, особенно в отдаленные эндемические районы планеты, а также при взаимодействии человека с дикими животными.
Факты
Малярия – это болезнь, вызываемая паразитическими простейшими плазмодиями, которые заражают в среднем 200 миллионов человек в год по всему земному шару. В результате по этой причине происходит 500 000 смертей. Возбудитель малярии попадает в организм при укусах малярийных комаров. Что происходит далее? Паразит малярии проходит сложный жизненный цикл в теле комара, а затем – в теле инфицированного. Цикл повторяется, если комар укусит человека, который уже заражен, и в его крови присутствует паразит, вызывающий заболевание «малярия». Фото возбудителя представлено ниже.

Районами с самой высокой смертностью от этого заболевания являются Африка, Азия, Центральная и Южная Америка. Малярия – болезнь, поражающая очень большое количество людей, посещающих эти области. В странах Африки южнее Сахары большинство заболевших (86%) – это дети в возрасте до 5 лет. Около 40% мирового населения находится в группе риска заражения. Инкубационный период составляет от одной до трех недель. Некоторые люди могут стать носителями так называемых спящих паразитов. В этом случае активация инфекции может произойти спустя несколько месяцев или даже лет после того как плазмодии малярии попадут в организм.
Признаки
Малярия – болезнь, симптомы которой включают озноб, лихорадку, головные и мышечные боли. У некоторых больных наблюдаются тошнота, рвота, кашель и диарея. Состояние лихорадки повторяется каждые один, два или три дня – это самое типичное проявление малярии. Дрожь и ощущение холода сменяются так называемой горячей стадией, для которой характерны высокая температура, судороги, головные боли и рвота.
Осложнения нередко являются признаками такой формы недуга, как тропическая малярия. Из-за разрушения красных кровяных телец и клеток печени может наблюдаться желтуха кожи и белков глаз, а также понос и кашель. В более редких случаях появляется сыпь на теле в виде зудящих красноватых папул. По таким признакам определяется малярия. Фото переносчика недуга представлено выше.
Тяжелые формы, например, если возбудителем малярии является Plasmodium falciparum, сопровождаются такими проблемами, как:
- кровотечения;
- печеночная и почечная недостаточность;
- шок и кома;
- поражение центральной нервной системы.
Без своевременного лечения эти симптомы нередко приводят к смерти.
Как она передается?
Итак, рассмотрим подробнее, как возбудитель малярии попадает в организм и развивается в нем. Жизненный цикл малярийного паразита Plasmodium является сложным, микроорганизм имеет двух хозяев – это человек и малярийный комар. Как было сказано выше, заболевание передается посредством укуса насекомого, при котором паразит попадает непосредственно в кровь.
Спорозоиты (незрелые плазмодии) путешествуют по кровеносному руслу человека и попадают в печень. Там они созревают и заражают красные кровяные клетки – эритроциты, внутри которых развиваются до тех пор, пока больного снова не укусит переносчик малярии – комар. Попадая в тело насекомого, плазмодии проникают в его слюнные железы, и при очередном укусе в виде спорозоитов снова начинают свой жизненный цикл в крови человека.
Процессы развития таких видов, как P. ovale и P. vivax, могут быть еще более сложными и включать образование неактивных форм – гипнозоитов, которые нередко остаются неактивными на протяжении нескольких недель и даже лет. В организме малярийного комара плазмодии проходят половой период своего жизненного цикла, а в теле человека возбудитель пребывает в бесполой фазе, которая также называется шизогонией. Поэтому цикл развития плазмодия в красных кровяных клетках носит название эритроцитарной шизогонии.
Как передается инфекция? Ее источниками являются самки малярийных комаров и зараженный человек (как больной, так и носитель). Стоит отметить, что малярия – это заболевание, которое не передается среди людей ни бытовым, ни воздушно-капельным путем. Заражение может произойти только в случае попадания крови больного в организм здорового человека.

Особенности диагностики
При появлении вышеперечисленных симптомов, особенно после путешествий, рекомендуется сдать анализы на наличие малярийного плазмодия. Проявления многих заболеваний могут напоминать симптомы малярии. Это, например, желтая лихорадка, брюшной тиф, грипп, холера, корь и туберкулез. Поэтому врач должен знать историю поездок заболевшего человека, чтобы назначить проведение необходимых анализов.
Диагностика малярии в первую очередь включает проведение классического и наиболее часто используемого теста – это изучение мазка крови на предметном стекле, при котором используется окрашивающий индикатор, указывающий на присутствие паразитов внутри красных кровяных телец. Несмотря на то что этот тест считается достаточно простым, правильность результатов во многом зависит от технического мастерства лаборанта, который подготавливает и рассматривает препараты крови под микроскопом.

Другие тесты, которые могут помочь в диагностике недуга:
- иммунологические анализы;
- полимеразная цепная реакция.
Лечение
Особенности терапии зависят от нескольких факторов:
- вид плазмодия, попавшего в организм;
- клиническая ситуация пациента, например, лечение будет разным для взрослого, ребенка и беременной женщины, для тяжелой и легкой формы недуга;
- лекарственная чувствительность возбудителя.
Последний фактор зависит от географической области, в которой была получена инфекция. Дело в том, что различные районы мира имеют разные виды малярийных плазмодиев, которые устойчивы к определенным препаратам. Средства от малярии могут быть подобраны правильно врачом, который знаком с информацией из протоколов лечения малярии в разных странах мира. Люди, зараженные видом возбудителя P. falciparum, могут умереть без своевременного начала лечения, поэтому терапевтические меры должны быть приняты немедленно.
Легкие формы малярии лечатся пероральными препаратами. Сложные симптомы, такие как тяжелая анемия, нарушения сознания, кома, отек легких, почечная недостаточность, острый респираторный синдром, диссеминированное внутрисосудистое свертывание крови, спонтанные кровотечения, ацидоз, присутствие гемоглобина в моче, желтуха и генерализованные судороги, требуют внутривенного введения лекарственных средств.

Лечение малярии в большинстве случаев основано на шаблонных схемах, принятых для того или иного региона. Например, возбудитель P. falciparum, приобретенный в странах Ближнего Востока, чувствителен к хлорохину, но если заражение этой же разновидностью малярии произошло в Африке, то данное вещество может не принести положительных результатов в лечении.
Современные ученые разработали схемы терапии, основанные на сочетании препаратов с производными активного противомалярийного соединения — артемизина. Примеры комбинированных лекарственных средств:
Разработка новых средств лечения малярии осуществляется постоянно, что связано с увеличением количества устойчивых к медикаментам штаммов плазмодия. Одним из перспективных соединений в создании действенных лекарств от малярии является спироиндолон, который оказался эффективным против разновидности возбудителя P. falciparum в ряде экспериментов.

Заболевание в период вынашивания ребенка
Заболевание у детей
Очень важно использовать правильную дозировку для ребенка, которая зависит от его возраста и веса. Все родители перед поездкой с малышом в страны, входящие в группу риска, должны проконсультироваться со специалистом в области детских инфекционных заболеваний по поводу лечения и профилактики рассматриваемого недуга. Так как передозировка противомалярийного препарата может оказаться смертельной, все лекарства необходимо хранить в недосягаемом для детей месте, например, в плотно закрытых контейнерах.
Профилактика заражения
Если человек намерен поехать в области, где распространена малярия, прежде всего он должен выяснить, какие средства и в каких дозировках нужно принимать для предотвращения инфицирования. При этом рекомендуется начать прием этих препаратов за две недели до предполагаемой поездки, во время пребывания в стране и на протяжении месяца после возвращения из путешествия. В настоящее время прививка от малярии не создана, однако ведутся интенсивные исследования, вакцина находится в стадии разработки.
По возможности избегайте посещения стран с высоким процентом инфицированных, в противном случае профилактика малярии обязательна – это может уберечь ваше здоровье и спасти жизнь. Если вы – путешественник, старайтесь всегда быть в курсе того, в каких местах отмечаются вспышки заболеваемости в настоящее время. Переносчик малярии может приземлиться на кожу человека в любое время суток, но большинство укусов приходится на ночь. Насекомые также наиболее активны на рассвете и в сумерках. Избегайте пребывания на открытом воздухе в эти часы. Профилактика заражения очень важна, учитывая то, что прививка от малярии не создана.

Вакцина
В настоящее время не существует доступных вакцин от малярии. Однако за последние несколько лет исследователи добились хороших результатов с экспериментальными вакцинами. Новейшие крупные клинические испытания с участием детей из восьми африканских стран, спонсируемые фондом Билла Гейтса, показали, что изучаемый препарат оказался эффективным в половине случаев. Многие другие эксперименты также стали успешными и пророчат надежную защиту от описанного недуга в ближайшем будущем. Специалисты говорят о том, что вакцина от малярии появится в течение 3-10 лет. Предполагаемое действие основано на прерывании жизненного цикла паразита с помощью препарата протеина, который вырабатывает антитела против него.
Типы болезни
Выше были названы основные разновидности возбудителей недуга. Различаться может и течение болезни. Назовем основные виды малярии:
- тропическая;
- трехдневная;
- четырехдневная;
- малярия-ovale.
Четырехдневная малярия проявляется шести-десятичасовой длительностью приступов лихорадки, которая обычно начинается утром или днем. Тяжелые последствия развиваются редко, инкубационный период может составлять до 5 месяцев. Тропическая малярия характеризуется высокой концентрацией паразитов в крови, лихорадка выражена нечетко, часто присутствуют такие симптомы, как диарея, рвота, поражения центральной нервной системы, почечная недостаточность. Нередко развиваются осложнения. Трехдневная малярия проявляется выраженной лихорадкой, включающей озноб, усиленное потоотделение и повышение температуры, но нечетким чередованием с периодами ремиссии.
Народные средства
Медикаменты – это основа лечения малярии. Но многие источники указывают на пользу некоторых натуральных средств в терапии заболевания, вызванного плазмодиями. Здесь мы публикуем только некоторые из них, при этом ни в коем случае эти рецепты и рекомендации нельзя рассматривать в качестве основных средств лечения.
Лайм и лимон являются полезными при четырехдневной лихорадке. Около трех граммов мела растворяют в 60 мл воды и добавляют сок одного лимона или лайма. Этот состав необходимо выпить до начала лихорадки.
Квасцы также рассматриваются в качестве поддерживающего средства при лечении малярии. Их обжаривают на раскаленной сковороде и измельчают в пудру. Внутрь принимают чайную ложку средства за четыре часа до предполагаемой лихорадки и половину чайной ложки через два часа после нее.
Рассмотрите рисунок, на котором представлен цикл развития печёночного сосальщика, и ответьте на вопросы.
Какой цифрой обозначен на рисунке промежуточный хозяин?
Рассмотрите рисунок, на котором представлен цикл развития человеческой аскариды, и ответьте на вопрос.
Какой цифрой обозначен на рисунке основной хозяин?
Рассмотрите рисунок, на котором представлен цикл развития аскариды, и ответьте на вопрос.
Какой цифрой обозначен на рисунке промежуточный хозяин?
Рассмотрите рисунок, на котором представлен цикл развития бычьего цепня, и ответьте на вопросы.
Какой цифрой обозначен на рисунке основной хозяин?
Рассмотрите рисунок, на котором представлен цикл развития бычьего цепня, и ответьте на вопросы.
Какой цифрой обозначен на рисунке промежуточный хозяин?
Рассмотрите рисунок, на котором представлен цикл развития кошачьей двуустки, и ответьте на вопросы.
Какой цифрой обозначен на рисунке основной хозяин?
Рассмотрите рисунок, на котором представлен цикл развития кошачьей двуустки, и ответьте на вопросы.
Какой цифрой обозначен на рисунке промежуточный хозяин?
Рассмотрите рисунок, на котором представлен цикл развития лентеца, и ответьте на вопросы.
Какой цифрой обозначен на рисунке основной хозяин?
Рассмотрите рисунок, на котором представлен цикл развития лентеца, и ответьте на вопросы.
Какой цифрой обозначен на рисунке промежуточный хозяин?
Рассмотрите рисунок, на котором представлен цикл развития лямблии, и ответьте на вопросы.
Какой цифрой обозначен на рисунке основной хозяин?
Рассмотрите рисунок, на котором представлен цикл развития лямблии, и ответьте на вопросы.
Какой цифрой обозначен на рисунке промежуточный хозяин?
Рассмотрите рисунок, на котором представлен цикл развития лямблии, и ответьте на вопросы.
Какой цифрой обозначен на рисунке основной хозяин?
Рассмотрите рисунок, на котором представлен цикл развития лямблии, и ответьте на вопросы.
Какой цифрой обозначен на рисунке промежуточный хозяин?
Рассмотрите рисунок, на котором представлен цикл развития малярийного плазмодия, и ответьте на вопросы.
Какой цифрой обозначен основной хозяин малярийного плазмодия?
Рассмотрите рисунок, на котором представлен цикл развития малярийного плазмодия, и ответьте на вопросы.
Какой цифрой обозначен на рисунке промежуточный хозяин?
Рассмотрите рисунок, на котором представлен цикл развития острицы детской, и ответьте на вопросы.
Какой цифрой обозначен на рисунке основной хозяин?
Рассмотрите рисунок, на котором представлен цикл развития острицы детской, и ответьте на вопросы.
Какой цифрой обозначен на рисунке промежуточный хозяин?
Рассмотрите рисунок, на котором представлен цикл развития печёночного сосальщика, и ответьте на вопросы.
Какой цифрой обозначен на рисунке основной хозяин?
Рассмотрите рисунок, на котором представлен цикл развития свиного цепня, и ответьте на вопросы.
Какой цифрой обозначен на рисунке основной хозяин?
Рассмотрите рисунок, на котором представлен цикл развития свиного цепня, и ответьте на вопросы.
Какой цифрой обозначен на рисунке промежуточный хозяин?
Рассмотрите рисунок, на котором представлен цикл развития трипаносомы, и ответьте на вопросы.
Какой цифрой обозначен на рисунке основной хозяин?
Рассмотрите рисунок, на котором представлен цикл развития трипаносомы, и ответьте на вопросы.
Какой цифрой обозначен на рисунке промежуточный хозяин?
Рассмотрите рисунок, на котором представлен цикл развития эхинококка, и ответьте на вопросы.
Какой цифрой обозначен на рисунке основной хозяин?
Рассмотрите рисунок, на котором представлен цикл развития эхинококка, и ответьте на вопросы.
Какой цифрой обозначен на рисунке промежуточный хозяин?
Рассмотрите рисунок, на котором представлен цикл развития эхинококка, и ответьте на вопросы.
Какой цифрой обозначен на рисунке основной хозяин?
Рассмотрите рисунок, на котором представлен цикл развития эхинококка, и ответьте на вопросы.
Какой цифрой обозначен на рисунке промежуточный хозяин?
Рассмотрите рисунок, на котором представлен цикл развития человеческой аскариды, и ответьте на вопросы.
Какой цифрой обозначен на рисунке орган, в котором обитает взрослая особь?
Рассмотрите рисунок, на котором представлен цикл развития малярийного плазмодия, и ответьте на вопросы.
Какой цифрой обозначен орган человека, в котором размножается малярийный плазмодий?
Рассмотрите рисунок, на котором представлен цикл развития печёночного сосальщика, и ответьте на вопросы.
Какой цифрой обозначена на рисунке ресничная личинка?
Рассмотрите рисунок, на котором представлен цикл развития человеческой аскариды, и ответьте на вопросы.
Какой цифрой обозначен на рисунке орган человека, в котором завершается личиночная стадия развития аскариды?
Малярийный плазмодий. Многие насекомые являются переносчиками опасных заболеваний. Малярийный комар, пожалуй, является самым известным представителем таких насекомых. Малярия – опасное заболевание, которое вызывается малярийным плазмодием. Заражение инфекцией происходит при укусе малярийного комара, в слюне которого могут содержаться специфические ферменты и спорозоиты плазмодия. В результате укуса у человека наступает мощная интоксикация организма, которая сопровождается сильнейшей лихорадкой.
Малярийные комары — переносчики малярийных плазмодиев
Переносить малярию способны только некоторые комары рода Anopheles. Их и называют малярийными комарами. Это довольно обширный род, включающий несколько сотен видов.Не все представители рода Анофелес способны переносить малярию. Некоторые являются очень хорошими переносчиками, другие же не опасны.

Эти комары широко распространены по всему миру. В том числе и в тех регионах, где малярия была ликвидирована. Встречаются они и в умеренном климате, есть они и в Московской и Ленинградской областях, Сибири, Дальнем Востоке.
Поэтому случаи местной малярии возможны и на территории России. Так как туристы, выезжавшие в неблагополучные регионы, или мигранты могут служить источником инфицирования комаров. Особенно высок риск в жаркие года. Личинки комаров развиваются в воде, поэтому их гораздо больше в сырых местах.
Наличие или отсутствие в организме комара возбудителя малярии никак не сказывается на его внешнем виде или поведении. Поэтому различить инфицированных и неинфицированных комаров без специального анализа невозможно.
После того как комар напился крови больного, должно пройти время, чтобы малярийный плазмодий прошел определенные стадии развития и комар стал заразным (обычно 10–20 дней). На скорость развития малярийных плазмодиев в организме комара влияет множество факторов, в том числе и температура. При низких температурах развитие замедляется или прекращается.

Так как комар живет недолго, то далеко не всегда он успевает стать заразным, погибая до того как возбудитель малярии завершит свое развитие. Это одна из причин того, что в умеренном климате местная малярия редка. К тому же с наступлением холодов прекращается циркуляция возбудителя между людьми и комарами.
Сами по себе комары не содержат возбудителей малярии. Чтобы действительно стать малярийными они должны напиться крови человека больного малярией. Комар может заразиться только от человека, потомству малярийный плазмодий не передается.
Одной из главных мер защиты является предотвращения укусов малярийных комаров. Это использование сеток и пологов (тем более, что большинство малярийных комаров предпочитает питаться ночью), распыление инсектицидов в помещениях, выбор времени и маршрутов, использование репеллентов.
Малярийный плазмодий – возбудитель малярийной инфекции. По классификации простейших (одноклеточных) паразитов относится к типу Apicomplexa, классу Sporozoa (Споровики), отряду Haemosporida, семейству Plasmodiidae, роду Plasmodium.
В человеческом организме способны паразитировать 4 вида паразита:
- Plasmodium vivax – возбудитель трёхдневной малярии;
- Plasmodium malariae – возбудитель четырёхдневной малярии;
- Plasmodium falciparum – возбудитель тропической малярии;
- Plasmodium ovale – возбудитель ovale – малярии, схожий с видом P. vivax.
Все разновидности в целом схожи по форме, строению и жизненным циклам, за исключением деталей. Но имеют свои особенности цикла развития; в основном — по продолжительности его периодов.
Цикл развития малярийного плазмодия
Малярийный плазмодий. Цикл развития малярийного плазмодия довольно сложен. При укусе комара, зараженного малярией, в кровь человека попадают спорозоиты (см. ниже). В теле человека спорозоиты прежде всего поступают в клетки ретикуло-эндотелнальной системы,образуя там первичные тканевые формы.
Этот период развития малярийного плазмодия протекает бессимптомно. В дальнейшем малярийные плазмодии поступают в кровь и внедряются в эритроциты, проделывая там цикл бесполого развития и размножения (шизогония).
Созревший шизонт дробится в эритроците на мерозоиты. После этого эритроцит разрушается, а мерозоиты выходят в кровь и внедряются затем в новые эритроциты, проходя там новый цикл развития.
При трехдневной малярии некоторые из мерозоитов могут поступать в клетки ретикуло-эндотелиальной системы и образовывать вторичные тканевые формы. Наличие вторичных тканевых форм обусловливает возможность появления рецидивов малярии.
Наряду с бесполыми формами (шизонтами) в эритроцитах могут образовываться и половые клетки — гаметы: мужские (микрогаметы) и женские (макрогаметы). Наличие в крови половых форм плазмодия не дает клинических проявлений, но опасно с эпидемиологической точки зрения: такие больные заразны для комаров.

Гаметы, поступая в организм комара, проходят там половой цикл развития, приводящий к образованию огромного количества спорозоитов, проникающих в слюнные железы комара и способных заражать человека.
Периоды и симптомы протекания болезни
Малярийный плазмодий. Весь процесс, от инфицирования до выздоровления, можно разделить на четыре периода: инкубационный, острый, скрытый и период рецидивов. Характер протекания болезни и периодичность рецидивов во многом зависит от вида малярийного плазмодия – возбудителя. Например, инкубационный период болезни может варьироваться от 7 дней до 1 года, в зависимости от разновидности малярийной инфекции.
Общие характерные признаки болезни:
На фоне протекания основного заболевания могут возникнуть и другие патологии, такие как ишемия сосудов головного мозга, некробиоз в почках. В случае осложнения болезни возможны кома, разрыв селезенки.
Размеры малярийного спазмодия
Жизненный цикл возбудителей малярии человека складывается из следующих этапов: полового процесса размножения в комарах (спорогония); бесполого размножения в клетках печени (тканевая шизогония); бесполого размножения в эритроцитах (эритроцитарная шизогония); формирования в эритроцитах половых форм — гаметоцитов.
В организм nopheles больного малярией или паразитоносителя в желудок насекомого попадают гаметоциты: макрогаметоциты (женские) и микрогаметоциты (мужские). После перестройки ядерного аппарата макрогаметоцит превращается в макрогамету. Из микрогаметоцита формируются 4—8 микрогамет.

В желудке комара происходит оплодотворение макрогаметы микрогаметой. В результате образуется подвижная зигота, называемая оокинетой. Последняя проникает через стенку желудка и на его наружной стороне формируется ооциста.
Ядра в ооцисте многократно делятся, после чего внутри ооцисты образуются спорозоиты — удлиненные веретеновидные тельца размером 11 —15 мк в длину.
Оболочка ооцисты разрывается и спорозоиты проникают в слюнные железы. При укусе комара спорозоиты попадают в организм человека. Продолжительность спорогонии зависит от температуры . При t° ниже 16° спорогония не происходит.
Малярийный плазмодий. Спорозоиты могут находиться в крови человека не более одного часа. В течение этого срока они проникают в клетки паренхимы печени, где образуются шизонты. Их развитие детально изучено на видах плазмодиев, паразитирующих у обезьян и частично на плазмодиях человека.

Спорозоит, проникнув в клетку печени, округляется, увеличивается в размерах, ядро образовавшегося шизонта последовательно делится. Паразит к 6—12-му дню заполняет всю печеночную клетку, оттесняя ядро клетки к периферии.
Размеры паразита — до 60 мк. Такой крупный шизонт распадается на большое число (тысячи и десятки тысяч) мерозоитов.
Эти последние у P. falciparum проникают в эритроциты и в дальнейшем паразиты развиваются только в эритроцитах; у других видов мерозоиты проникают в эритроциты, а также и в клетки паренхимы печени, где проделывают последующие циклы тканевой шизогонии. Продолжительность тканевого развития у Р. vivax vivax и P. ovale 7—8 дней, P. malariae 11 — 12 дней.
Тканевые мерозоиты проникают в эритроцит и образуют шизонты, которые распадаются на эритроцитарные мерозоиты. Эритроциты разрушаются и освободившиеся мерозоиты поселяются в новых эритроцитах.
Малярийный плазмодий. А счет некоторой части мерозоитов образуются гаметоциты. Последние длительное время могут циркулировать в крови, их дальнейшее развитие (спорогония) происходит в переносчике. Разные стадии развития возбудителей малярии в крови хорошо различимы по морфологическим признакам. Однако P. vivax vivax от P. vivax hibernans отличить не удается.
Морфологические особенности самих возбудителей и вызываемых ими изменений в эритроцитах позволяют на препаратах (мазках и толстых каплях крови) определить вид паразита. В эритроцитарном цикле развития плазмодиев различают следующие стадии: кольца, шизонта, меруляции, молодые и сформировавшиеся гаметоциты.
Развитие эритроцитарных стадий всех видов возбудителей малярии человека происходит в циркулирующей крови. Исключение составляет P. falciparum, у которого в крови обнаруживаются только стадии кольца и гаметоциты; дальнейшее развитие шизонтов вплоть до освобождения мерозоитов из эритроцитов происходит в капиллярах, в которых находится депонированная кровь.
Строение малярийного плазмодия
Малярийный плазмодий. Тип Споровики (Sporozoa): к типу относятся исключительно паразитические простейшие. В связи с паразитическим образом жизни происходит упрощение организации (исчезновение органоидов захвата и приема пищи, пищеварительных и сократительных вакуолей). Происходит усложнение жизненного цикла — смена хозяев, чередование бесполого и полового размножения. Представитель типа — малярийный плазмодий.
Спорозоиты — тонкие, червеобразные клетки, с током крови попадают в клетки печени, где превращаются в шизонтов, которые размножаются множественным делением — шизогонией. При этом ядро многократно делится, затем из каждой клетки образуется большое количество дочерних клеток.
Образовавшиеся мерозоиты выходят из клеток печени и внедряются в эритроциты. Здесь они питаются, затем вновь происходит шизогония. Таким образом, различают две формы шизогонии — в клетках печени и в эритроцитах.
Малярийный плазмодий вызывает у человека заболевание малярией. Заражение происходит через укус малярийным комаром (рода Anopheles), который содержит возбудителя на стадии спорозоитов.
В результате эритроцитарной шизогонии образуются 10—20 мерозоитов, которые разрушают эритроцит, выходят в кровь и заражают следующие эритроциты. Цикличность приступов малярии обусловлена цикличностью выходов мерозоитов и продуктов их метаболизма из эритроцитов в плазму крови.
После нескольких циклов шизогонии в эритроцитах образуются гамонты, которые в организме комара превратятся в макрогаметы и микрогаметы. Когда гамонты попадают в желудок комара, они превращаются в гаметы, происходит копуляция, слияние гамет. Зигота подвижна и называется оокинета.

Оокинета мигрирует через стенку желудка комара и превращается в ооцисту. Ядро ооцисты многократно делится, и ооциста распадается на огромное количество спорозоитов — до 10000. Этот процесс называется спорогония. Спорозоиты мигрируют в слюнные железы комара. Мейоз происходит после образования зиготы, спорозоиты гаплоидны.
Таким образом, в жизненном цикле малярийного плазмодия человек является промежуточным хозяином (преэритроцитарная шизогония, эритроцитарная шизогония, начало гаметогонии), а малярийный комар — окончательным (завершение гаметогонии, оплодотворение и спорогония).
Где обитает малярийный плазмодий и чем он опасен для здоровья человека
Малярия — крайне опасное заболевание, потому немаловажно знать, где обитает малярийный плазмодий и чем он опасен для человека. Плазмодий — это одноклеточный паразит, способный приносить вред здоровью не только животных, но и человека. В мире насчитывают порядка 200 видов данного паразита, из которых только 4 вида представляют опасность для здоровья человека.
Шизогония
Малярийный плазмодий. Plasmodium vivax вызывает трехдневную малярию, Plasmodium malariae — четырехдневную, Plasmodium falciparum — тропическую, Plasmodium ovale — овале-малярию, которая в основном характерна для жителей Центральной Африки.
Французским физиологом Шарлем Луи Альфонсом Лавераном в 1890 году был открыт малярийный плазмодий человека. С 2004 года указывают еще на 1 вид — Plasmodium knowlesi, обитающий в Юго-Восточной части Азии. Кроме того, последний тип способен вызвать малярию у длиннохвостых макак (макаки-крабоеды, или яванские макаки).
Во время укуса комаром Анофелес происходит поступление в кровь человека слюны, содержащей специфические ферменты, блокирующие свертывание крови, и спорозоиты плазмодия. Спорозоиты являются изогнутыми, веретенообразными, длиной до 15 мкм формами плазмодиев.
С током крови по сосудам спорозоиты попадают в клетки печени человека, где и начинается бесполое размножение паразита. Шизогония плазмодиев имеет отличительные особенности: материнская клетка в результате деления образуется не 2 дочерние, как у других представителей, а множество.
За время тканевой и эритроцитарной шизогонии в протоплазме (внутреннее содержимое клетки) мерозоитов происходит формирование пищеварительных вакуолей. В этих вакуолях происходит скопление необходимых для плазмодиев питательных веществ и выведение из них продуктов жизнедеятельности (токсинов), не нужных плазмодию и вредных для человека.
Не во всех эритроцитах формируются новые мерозоиты, в некоторых происходит формирование мужских и женских половых клеток — гамонтов (гемотоцитов). Выходя из разрушенных эритроцитов, мерозоиты проникают в другие (здоровые) и заново делятся, вскоре разрушив и эти эритроциты.

Такие повторные переходы происходит с постоянной частотой: у Plasmodium malariae каждые 72 часа, а у остальных видов плазмодиев — каждые 48 часов. С этой же частотой у больного малярией наблюдаются симптомы интоксикации (так как в кровь выходят токсины): озноб и очень высокая температура тела. Эти циклы эритроцитарной шизогонии будут повторяться до тех пор, пока не образуется необходимое для дальнейшего развития число мерозоитов.
За время тканевой и эритроцитарной шизогонии в протоплазме (внутреннее содержимое клетки) мерозоитов происходит формирование пищеварительных вакуолей. В этих вакуолях происходит скопление необходимых для плазмодиев питательных веществ и выведение из них продуктов жизнедеятельности (токсинов), не нужных плазмодию и вредных для человека. Не во всех эритроцитах формируются новые мерозоиты, в некоторых происходит формирование мужских и женских половых клеток — гамонтов (гемотоцитов).
Спорогония
После того как произошло несколько циклов шизогонии и сформировались гамонты, начнется следующая стадия жизненного цикла плазмодиев. Но для этого необходимо совершить переход в тело основного хозяина — комара. Это происходит при укусе комаром зараженного человека. Вместе с выпившей кровью в организм комара проникают гамонты.
Затем в полости желудка комара происходит формирование из гамонтов зрелых половых клеток — гамет и их слияние (оплодотворение). В результате оплодотворения формируется зигота, проникающая в стенку желудка.
Созревшие спорозоиты из стенки желудка комара переходят в его слюнные железы, а затем во время укуса комаром человека со слюной проникают в кровь человека. И с этого момента начинается весь жизненный цикл малярийного плазмодия заново.
Здесь зигота становится растущей и развивающей ооцистой, которая многократно делясь, образует тысячи новых спорозоитов. Процесс формирования новых, способных к репродукции путем шизогонии, спорозоитов в организме комара, продолжается 7-45 дней. На эту продолжительность влияет температура окружающей среды: чем она выше, тем быстрее стадия спорогонии.
Симптоматика малярийного плазмодия: малярия
Малярийный плазмодий. Люди, зараженные малярийным плазмодием, находятся в серьезной опасности, так как их организм подвергается мощной интоксикации с возможными многочисленными осложнениями. Во время выхода мерозоитов из эритроцитов и гепотацитов в кровь человека поступает большое количество токсинов, образованных в результате жизнедеятельности самих мерозоитов и в результате распада гемоглобина.
Эта интоксикация сопровождается приступообразным повышением температуры тела (порой до 41ºС), ознобом, головными и мышечными болями, сильной слабостью. Приступы лихорадки длятся от 1,5 до 2 часов. После лихорадки отмечается возникновение сильной жажды, сухости во рту, чувства жара. Когда температура приходит в норму, все другие проявления прекращаются, наступает облегчение и больной засыпает.
На всем протяжении болезни происходит от 10 до 15 приступов, после чего в крови формируются антитела в ответ на антигены паразитов. Больной не испытывает симптомов заболевания, но остается опасным для окружающих, так как некоторые мерозоиты и гамонты по-прежнему продолжают жить в крови больного.
Подобные приступы при четырехдневной малярии наступают через каждые 72 часа. У некоторых больных этим видом малярии отсутствуют симптомы. Трехдневная и овалемалярия сопровождаются приступами лихорадки через каждые 48 часов.
И при укусе такого паразитоностителя в теле комара продолжится жизненный цикл плазмодия. Заразиться малярией можно не только от комаров, но и при переливании крови, взятой от донора-паразитоносителя. Это случается из-за того, что в эритроцитах донорской крови не всегда можно обнаружить шизонты плазмодиев, так как на момент исследования они могут находиться в гепатоцитах.
Читайте также:







